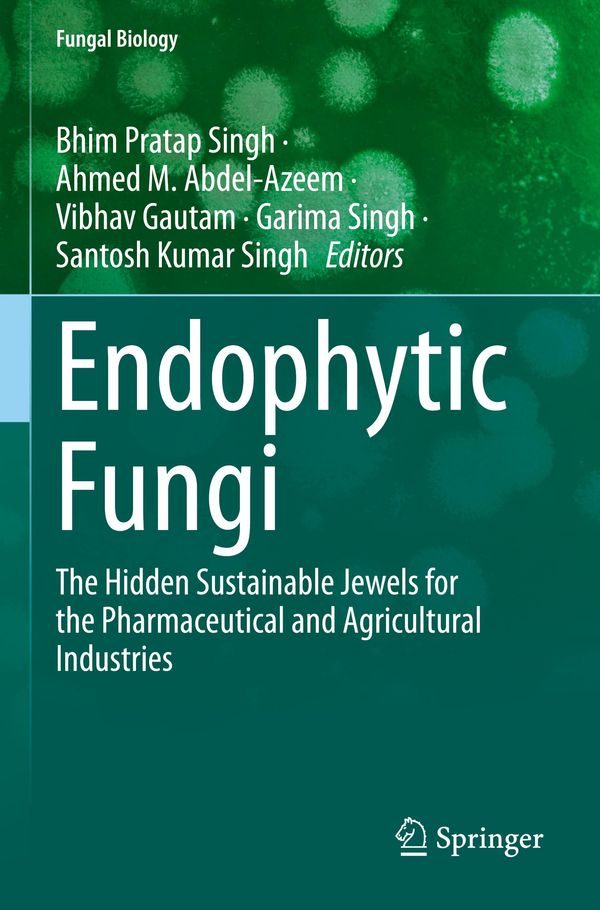
Endophytic Fungi

DIN 913/ISO 4026 Gewindestift VG M14x60 Stahl 45H galvanisch verzinkt Innensechskant m. Kegelkuppe ; Industrial Quality Supplies
€49.99
inkl. MwSt. zzgl. Versand
Versand: €5.95

Rechteckige Tischsets in Gold, 4 Stück, Tischunterlage für Esstisch, Blattform, Abwaschbar, Rutschfest, Hitzebeständig, für Hochzeiten, Dinnerp...
€47.95
inkl. MwSt. zzgl. Versand
Versand: €0.00

Bouleset aus Holz - Jeu de boules - Hyper Luxe - in stabiler Tasche - ECO Holz aus Indien - Schön lackiert - 8 Stück mit Entfernungsmesser
€69.00
inkl. MwSt. zzgl. Versand
Versand: €0.00

Amsterdam Expert Series Acrylfarbe Flasche 400 ml Permanentgelb Dunkel 285
€32.88
inkl. MwSt. zzgl. Versand
Versand: €6.37

Spannbild ️ Blumen in voller Pracht | Hochformat | BigBilder 90 x 120 / Rahmen als Bausatz
€349.00
inkl. MwSt. zzgl. Versand

Bild 90x60cm Tropische Knabberei
€38.11
inkl. MwSt. zzgl. Versand
Versand: €9.90

Biofinity XR (3 linsen) Stärke: +14.00, BC: 8.60, DIA: 14.00
€19.62
inkl. MwSt. zzgl. Versand
Versand: €2.99

Uhlsport SCORE TRACK PANTS 3XL marine/fluo rot
€10.18
inkl. MwSt. zzgl. Versand
Versand: €5.99

Beetrose Melrose, kräftig rosa, starker Duft, RVS, 1985 - Co. 5 L
€18.50
inkl. MwSt. zzgl. Versand
Versand: €7.49

VOLVO XC90 Türverkleidung rechts hinten Holz 32328494 OE
€349.99
inkl. MwSt. zzgl. Versand
Versand: €0.00

Leinwandbild ️ Holztreppe auf Berg mit Wolken | Querformat | wandbild.com 160 x 120 / Stärke 2 cm
€239.00
inkl. MwSt. zzgl. Versand

Karol Szymanowski: Klavierwerke (CD)
€19.99
inkl. MwSt. zzgl. Versand
Versand: €0.00

Love, Naturally
€19.57
inkl. MwSt. zzgl. Versand
Versand: €1.90

Design Sitzer Luxus beige Sessel Relax Textil mit Edelstahl Sessel Club
€699.00
inkl. MwSt. zzgl. Versand
Versand: €0.00

Mein tröstliches Buch, Gebundene Ausgabe von Moni Port, Klett Kinderbuch, 978-3-95470-294-7
€16.00
inkl. MwSt. zzgl. Versand
Versand: €0.00

Autositzbezüge Universal Schonbezüge PKW Auto Set 1+1 Vorne für Citroen Berlingo
€51.45
inkl. MwSt. zzgl. Versand
Versand: €4.90

Russell Collection - Hemd für Damen kurzärmlig RW9398 (M) (Schwarz)
€33.49
inkl. MwSt. zzgl. Versand
Versand: €2.70

VAR Super mit ME-Deckel enzianblau
€144.99
inkl. MwSt. zzgl. Versand
Versand: €5.95

Und was bringt mir das beim Frühstück? HypnoSystemische Interventionen im Kontext der stationären Kinder- und Jugendhilfe, Taschenbuch von Gundula E.
€27.95
inkl. MwSt. zzgl. Versand
Versand: €0.00

WiarygodnoϾ. Sekret dobrych relacji Piotr Sztompka (Buch auf Polnisch)
€3.89
inkl. MwSt. zzgl. Versand
Versand: €10.99

SNR Generatorfreilauf Riemenscheibe Lichtmaschine für VW Golf IV Schrägheck (1J1)
€19.09
inkl. MwSt. zzgl. Versand
Versand: €7.10
EXKLUSIV HEIMTEXTIL Badetuch Frottier 500g/m² 100 x 150 cm Kiwi
€21.25
inkl. MwSt. zzgl. Versand
Versand: €0.00

Stolz und Vorurteil
€9.99
inkl. MwSt. zzgl. Versand
Versand: €3.99

Maison Exclusive - Massivholzbett Schwarz 140x190 cm
€219.95
inkl. MwSt. zzgl. Versand
Versand: €0.00

Herren Grafik T-Shirt Alle Macht den Logikern – Power To The Logicians – Öko-Verantwortlich Vintage Jahrgang Kurzarm Lustige Druck Geburtstag ...
€20.95
inkl. MwSt. zzgl. Versand
Versand: €4.95

Badheizkörper elektrisch mit analogem Thermostat weiß / 1160 x 600
€404.00
inkl. MwSt. zzgl. Versand

Heideman Damenring Lynn silberfarben poliert 58 (18.5) Damen
€29.99(€29,990.00 / ct)
inkl. MwSt. zzgl. Versand
Versand: €4.95

Hähnchenbrust-Knochies - | hunde-kausnacks.de
€0.89
inkl. MwSt. zzgl. Versand
Versand: €4.90

Magisches Rubbellos Europäische Städte (4 Stk.) 20x15 cm
€15.99
inkl. MwSt. zzgl. Versand
Versand: €0.00

Damen Vero Moda VMMAYA AVA SS TOP JRS, Braun, M, Damen-Blusen, Tuniken-Freizeit-Blusen
€24.99
inkl. MwSt. zzgl. Versand
Versand: €4.90

Belly Full Of Christmas Spirit Weihnachtsmann Santa Wein Lustig Damen T-Shirt, Rot, XXL
€19.95
inkl. MwSt. zzgl. Versand
Versand: €0.00

1:12 Puppenhaus-Bücherregal aus Holz, simuliertes Miniatur-Bücherregal, Schrank, Möbel, Dekoration, Zubehör
€21.99
inkl. MwSt. zzgl. Versand
Versand: €0.00

ISO13918-1 SZ M 5x10 Aluminium AlMg3 Schweißbolzen mit Spitzenzündung
€25.48
inkl. MwSt. zzgl. Versand
Versand: €5.90

Mr. & Mrs. Panda Turnschuhe Damen Kaktus Sonne Größe 37 1/2 - Grün - Geschenk, Freundin, Sneaker, Glück, Neustart, Damensneaker, Halbschuhe, Sp...
€76.99
inkl. MwSt. zzgl. Versand
Versand: €4.90

Duschhocker Drive Delphi Plus
€74.00(€74,000.00 / ct)
inkl. MwSt. zzgl. Versand
Versand: €0.00

GATES 09-0397 Turbo Ladeluftschlauch passend für MERCEDES-BENZ E-Klasse Limousine (W211) E-Klasse T-modell (S211)
€63.85
inkl. MwSt. zzgl. Versand
Versand: €7.10

Leinwand Bilder 20x30 cm - Kinder Mädchen - Einhorn - Prinzessin, Bilder Wohnzimmer Modern, Wanddeko
€24.90
inkl. MwSt. zzgl. Versand
Versand: €0.00

VAN WEZEL 8301K711 7VS16E Klimaanlage Klimakompressor PAG 46 YF R134a für KIA CARENS IV
€560.26
inkl. MwSt. zzgl. Versand
Versand: €0.00

Calvin Klein Jeans Farmer '90s' Férfi kék , Méret 34
HUF 50,990.00
inkl. MwSt. zzgl. Versand

FEBI BILSTEIN Kipphebel, Motorsteuerung 27552 für A541 050 05 34
€21.57
inkl. MwSt. zzgl. Versand

Haikyu!! - Osamu Miya Posing Figure - Banpresto
€39.95
inkl. MwSt. zzgl. Versand
Versand: €13.90

vidaXL Markise Manuell Einziehbar mit Rollo 4x3 m Orange & Braun - Markisen
€452.95
inkl. MwSt. zzgl. Versand
Versand: €0.00

Gira ABD.+ KNEBEL F.ZEIT.+JALOUSIE. (066628 ANTH. SYST.55)
€16.67
inkl. MwSt. zzgl. Versand
Versand: €0.00

ABAKUHAUS Lebkuchenmann Kissenbezug Set (4 Stück), Candy Red Star, Moderner Doppelseitiger Digitaldruck, 50 cm x 50 cm, Sand Braun Orange
€20.99
inkl. MwSt. zzgl. Versand
Versand: €0.00

Marabu Stoffmalstift Textil Painter Plus kupfer 787
€6.69
inkl. MwSt. zzgl. Versand
Versand: €0.00

Greiff Corporate CASUAL Damen Hose 5-Pocket Regular-Fit Marine 54
€73.66
inkl. MwSt. zzgl. Versand
Versand: €0.00

EDITED Rock 'Giselle' Damen Größe 40 schwarz
€54.90
inkl. MwSt. zzgl. Versand
Versand: €0.00

Needle Felting for Beginners
€16.87
inkl. MwSt. zzgl. Versand
Versand: €0.00

Eaton SH0635/3 Sammelschienenträger (058247)
€22.49
inkl. MwSt. zzgl. Versand
Versand: €4.95

Schmuckset Armband Halskette 15 rosa Opalperlen 8 mm Edelstahlkette
€41.05
inkl. MwSt. zzgl. Versand
Versand: €4.90

240-W-Schnellladekabel mit klappbarem Ständer und integriertem, um 360° drehbarem Typ-C-Anschluss
€13.89
inkl. MwSt. zzgl. Versand
Versand: €2.50

Poster mit Rahmen Gold "Junge Katze" artboxONE - Tiere - Tiere,Stubentiger,Zoo,Wild,Kinder,Natur,Wildlife,Haustier,Katze,Bunt
€54.99
inkl. MwSt. zzgl. Versand

Rusty Neal Hemd Herren Größe XL ecru / navy
€44.90
inkl. MwSt. zzgl. Versand
Versand: €0.00

Briefpapier Osterhase (250 Blatt) schönes Motivpapier Ostern DIN A4 90g farbig, selbst bedruckbar
€35.00
inkl. MwSt. zzgl. Versand
Versand: €0.00

Jack & Jones Junior Nadrág 'Paul' Fiúk szürke , Méret 152
HUF 19,490.00
inkl. MwSt. zzgl. Versand

2x kristallklare Schutzfolie für Lenovo IdeaPad Slim 5i Gen 8 14 Zoll - antibakteriell kristallklar Premium Displayschutz
€14.95
inkl. MwSt. zzgl. Versand
Versand: €0.00

Praktische Bunte Diamant Malerei Tragetasche - Wiederverwendbare Tasche für Schule, Picknick, Reisen - BB024
€43.95
inkl. MwSt. zzgl. Versand
Versand: €0.00

DFV mobile - Horizontale Mehrzweck-Gürteltasche mit Reißverschluss und Handschlaufe für LG K7 (LG M1) - Schwarz (15.5 x 8.5 cm)
€24.95
inkl. MwSt. zzgl. Versand
Versand: €0.00

Blue Wave Damen Steppweste Olivia mit Stehkragen - Gesteppte Weste packable inkl. Packbeutel in Grün Größe 46
€49.95
inkl. MwSt. zzgl. Versand
Versand: €4.95

4 Reifendrucksensoren RDKS Sensoren Metallventil Schwarz für Citroen C-Cactus/C4-Cactus E3 07.2014-12.2016
€74.89
inkl. MwSt. zzgl. Versand
Versand: €0.00

Vollgarage passend für Geely Cowboy SX12 Geländewagen SUV 5-türer 01.24-
€69.95
inkl. MwSt. zzgl. Versand
Versand: €0.00

Simpex Wohnteppich und Kurzflor, Waschmaschinenfest, Allergikerfreundlich und Weicher Teppich, Größe: 160 x 220 cm, Farbe: Grau
€49.90
inkl. MwSt. zzgl. Versand
Versand: €0.00

PRASKDESIGN Doppelrollo Tag & Nacht mit Kassette & Führungsschienen - 52x150 cm - Innenrollo - lichtregulierend - Sonnenschutz - viele Farben
€28.38
inkl. MwSt. zzgl. Versand
Versand: €12.00

Herren Baumwollsocke FASHION TWO TONE mit Blockringel-Design blau-39-42
€7.00
inkl. MwSt. zzgl. Versand
Versand: €4.95

Coloray Bild aus Leinwand 100x50 Leinwand Dekoration - Wellen Fantasie
€119.99
inkl. MwSt. zzgl. Versand
Versand: €0.00

Premium-Fußmatten für: Alfa Romeo Giulia 2x4 (2WD) Limousine (2016-)
€56.99
inkl. MwSt. zzgl. Versand
Versand: €0.00

Versandkarton Faltkarton Versandschachtel Verpackung Wellpappe Kartons Pos. 3 (350x250x180 mm ) 20 Stück
€16.69
inkl. MwSt. zzgl. Versand
Versand: €0.00

Horseware Outdoordecke Rambo 1680D Wug Turnout, 0 g, High Neck
€354.95
inkl. MwSt. zzgl. Versand
Versand: €0.00

Diablo Keramik Becher Teebecher Kaffebecher Trinkbecher 300 ml Weiß-Blau
€11.99
inkl. MwSt. zzgl. Versand
Versand: €0.00
Endophytic Fungi
€197.13
inkl. MwSt. zzgl. Versand
Versand: €0.00

Herren Grafik T-Shirt Sei mutig sei frei genieße den Sommer in araceli – Be Brave Be Free Enjoy The Summer In Araceli – Öko-Verantwortlich Vi...
€21.95
inkl. MwSt. zzgl. Versand
Versand: €4.95

10 Premium Staubsaugerbeutel kompatibel für Electrolux Z 5503 Oxygen
€11.49
inkl. MwSt. zzgl. Versand
Versand: €6.90

vidaXL Couchtisch Schwarz 80x50x40 cm Massivholz Mango
€101.99
inkl. MwSt. zzgl. Versand
Versand: €0.00

Skiträger ausziehbar + Dachträger VDP EVO Stahl kompatibel mit Seat Altea (5P) 5 Türer 2004-2015
€219.95
inkl. MwSt. zzgl. Versand
Versand: €0.00

Ritzel mit 11 Zähnen in der Teilung 520 für Husqvarna FC 450 Baujahr 2014-2021 von JT-sprockets - Neu
€26.90
inkl. MwSt. zzgl. Versand
Versand: €0.00

JAN N JUNE Damen Bluse "LAIDE", L / Cherry Red White Striped - fair - nachhaltige B-Ware
€115.00
inkl. MwSt. zzgl. Versand
Versand: €4.90

Kinder T-Shirt Thundercats 02, 7-8 Jahr - 128 / Weiß
€13.90
inkl. MwSt. zzgl. Versand
Versand: €3.90

MuchoWow Glasbilder - Bilder auf Wandbild - Foto auf Glas Formen - Blau - Abstrakt 30x30 cm Wanddekoration aus Glas - Acrylglasbild - Acrylbilder
€29.99
inkl. MwSt. zzgl. Versand
Versand: €0.00

HP 963 4er-Pack OriginalDruckerpatronen Schwarz/Cyan/Magenta/Gelb
€109.51
inkl. MwSt. zzgl. Versand
Versand: €0.00

BATON ROUGE X11LS/F-SBB Folk
€219.00
inkl. MwSt. zzgl. Versand
Versand: €1.19

Cameo Color Haarfarbe 8/45 hellblond rot-mahagoni 60 ml
€7.75(€129.17 / l)
inkl. MwSt. zzgl. Versand
Versand: €4.99

vidaXL Bettgestell mit Kopf- und Fußteil Metall Schwarz 107x203 cm - Betten & Bettgestelle
€114.95
inkl. MwSt. zzgl. Versand
Versand: €0.00

Equitheme Sehnenstiefel Cob Cob
€28.49
inkl. MwSt. zzgl. Versand
Versand: €0.00

2x TEXTAR Bremsscheibe PRO 92197803
€114.41
inkl. MwSt. zzgl. Versand

Servietten Birdy - Symbole & Muster - von „Kathrin Woo"; Muster, Blumen, Vogel, verspielt, landhaus, Blumenmuster, Landhauss...
€18.95
inkl. MwSt. zzgl. Versand
Versand: €5.95

MuchoWow Handyhülle Schutzhülle Hülle für Samsung Galaxy S21 Plus Sonnenuntergang - Blumen - Rosa - Natur - Grün Silikon Softcase Handy Hül...
€15.99
inkl. MwSt. zzgl. Versand
Versand: €0.00

Kraft-Steckschlüssel-Einsatz, 6-kt., L, 25 mm (1"): 19x90 m
€41.46
inkl. MwSt. zzgl. Versand
Versand: €4.90

Parisian Kurzer Jumpsuit Allover-Druck Gr. 42 Damen
€22.44
inkl. MwSt. zzgl. Versand
Versand: €0.00

Dometic Midi Heki Style Dachhaube, 70x50cm, grau, Kurbel, o. Zwangsbelüftung
€629.00
inkl. MwSt. zzgl. Versand
Versand: €0.00

Grinch Herzbrille rosa Weihnachtshut Herzen Valentinstag Retro Herren T-Shirt, Navy, XXL
€19.95
inkl. MwSt. zzgl. Versand
Versand: €0.00

MuchoWow Poster Pfau - Federn - Vogel - Kinder - Jungen - Mädchen 80x40 cm - Wanddeko
€24.99
inkl. MwSt. zzgl. Versand
Versand: €0.00

Die Käserei in der Vehfreude, Gebundene Ausgabe von Jeremias Gotthelf , Philipp Theisohn, Diogenes Verlag AG, 9783257073034
€34.00
inkl. MwSt. zzgl. Versand
Versand: €0.00

ASA Henkelbecher 400ml Coppa Dogs
€14.90
inkl. MwSt. zzgl. Versand
Versand: €5.99

QUINTON HAZELL QTS840128 Gasfeder Heckklappendämpfer für VW Golf III Cabrio (1E7) 175mm
€20.63
inkl. MwSt. zzgl. Versand
Versand: €0.00

Nordcap Fleecejacke uni, pflegeleicht und schnelltrocknend
€29.99
inkl. MwSt. zzgl. Versand
Versand: €0.00

Sei du meine Stärke
€18.00
inkl. MwSt. zzgl. Versand
Versand: €0.00

Lustige Renten/ Ruhestands Karte: Endlich Rentier
€2.95
inkl. MwSt. zzgl. Versand
Versand: €2.99

Spiro - "Impact" Sweat-Shorts für Damen FK1523 (XXS) (Schwarz)
€12.15
inkl. MwSt. zzgl. Versand
Versand: €2.70

Ladekantenschutz Edelstahl innen Chrom passend für VW Tiguan II | BJ ab 2016>
€39.95
inkl. MwSt. zzgl. Versand
Versand: €0.00

Fliesenaufkleber Für Bad, Küche etc Haselnussbaun 83 glänzend 14,8 x 19,7 cm 25 Stück
€17.90
inkl. MwSt. zzgl. Versand
Versand: €6.90

